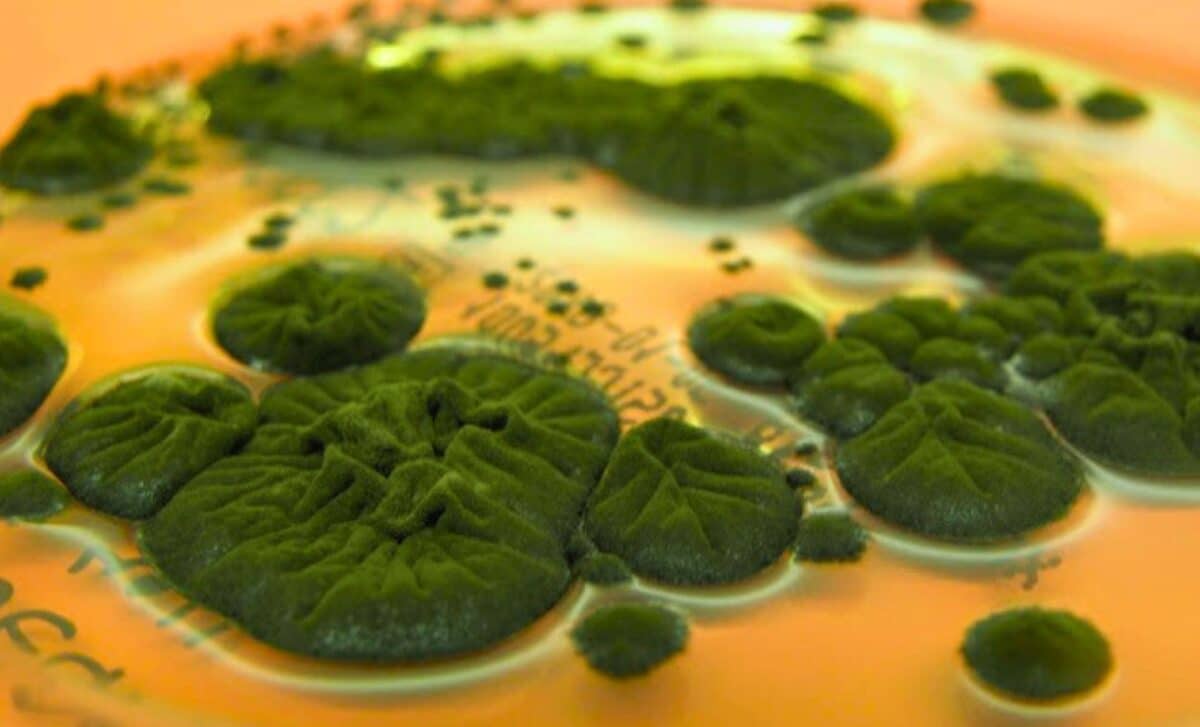
Featured image for Chernobyl Fungus Evolves Unique Radiation-Absorbing Ability

Tennessee Faces a Deadly Histoplasmosis Cluster Tied to Bat-Soiled Soil
Health officials in middle Tennessee report at least 36 histoplasmosis cases since last fall, with a possible related death; the source hasn’t been identified. Histoplasmosis is caused by inhaling Histoplasma spores found in soil rich with bird or bat droppings, and it’s not transmitted person-to-person. The cluster has prompted warnings for clinicians to consider histoplasmosis in patients with unexplained fever or respiratory illness, with past outbreaks linked to bat caves and bat guano use; investigators are continuing to search for the source.